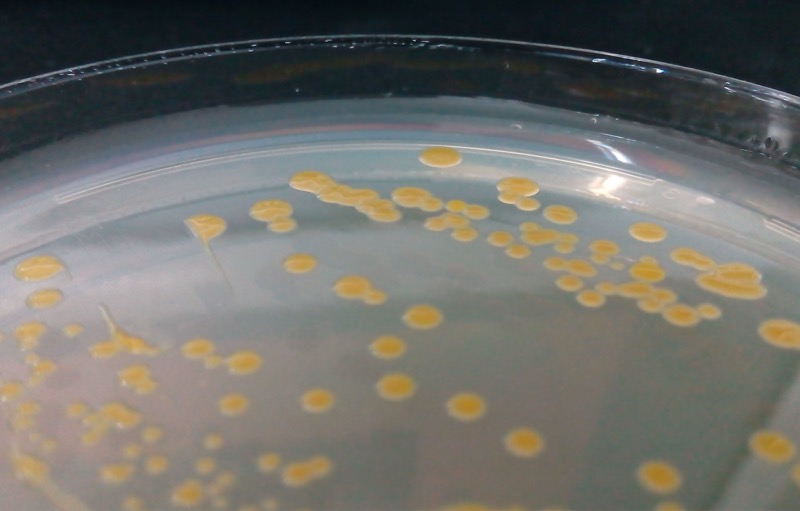

Uso de antimicrobianos en agua dulce: Avances y brechas pendientes
Por Rubén Avendaño Herrera, Académico de la Universidad Andrés Bello (UNAB) e Investigador Principal de la línea “Salud animal en estadios tempranos de salmónidos y recurso s nativos”, del Centro INCAR.

A 5 años de la publicación del Policy Brief “Pisciculturas de agua dulce: El gran pendiente de la industria salmonera chilena”, se podría indicar que las empresas han mejorado en algunos aspectos operativos, como la densidad de cultivo, estableciendo la mayoría de ellas estándares de bienestar animal.
Por otro lado, en la actualidad se puede contar anualmente con el “Informe con Antecedentes Sanitarios de Agua Dulce y Mar”, situación que antes de la publicación científica “Proper antibiotics use in the Chilean salmon industry: Policy and technology bottlenecks” de Aquaculture 495:803-805, no ocurría, ya que solo se mostraban los datos asociados a mortalidades en la fase marina.
Sin embargo, persiste la ausencia de una norma que regule el tratamiento del agua después de su uso, aunque el aumento de pisciculturas de recirculación ha permitido que la calidad del agua sea óptima debido al propio reuso que estas instalaciones requieren.
Otro de los temas pendientes planteados en el Policy Brief —y que, destacaría como la principal deuda— es el establecimiento de un Programa de Monitoreo Activo para F. psychrophilum, el principal patógeno de agua dulce y segunda causa de uso de antimicrobianos en esta etapa de cultivo.
La situación en estos más de diez años desde su inclusión en la Lista 3 ha experimentado un notorio cambio, debido a que distintos grupos de investigación han generado suficiente evidencia científica para abrir la discusión sobre la necesidad de un Programa Activo. Hoy existe evidencia sólida que demuestra que el transporte de peces junto a su microbiota, concretamente F. psychrophilum, ha provocado una gran diversidad genética y antigénica, incluso con grupos específicos solo para Chile, cuando se comparan con más de 1500 aislados de distintos países.
También se ha demostrado la co-ocurrencia de más de un aislado bacteriano en infecciones de salmón del Atlántico y trucha arcoíris, siendo estos últimos más virulentos. Todo ello conlleva la necesidad de mejorar las vacunas existentes y aún se investiga si esta diversidad impacta en la eficacia de los tratamientos antimicrobianos.
Ciertamente, los costos económicos asociados a infecciones en peces menores a 10 gramos no se comparan con las pérdidas que generan los patógenos en peces de más de 300 gramos en jaulas marinas. No obstante, la premisa de que en agua dulce se realizan los primeros tratamientos antimicrobianos —y que su eficacia podría disminuir cuando los peces son tratados en mar— sigue siendo una hipótesis que debiera comprobarse.
El panorama de la flavobacteriosis bajo un escenario de cambio climático no es alentador, especialmente considerando el aumento de pisciculturas de recirculación en los últimos cinco años. En un estudio realizado en el INCAR y publicado en Climate Risk Management (2023; 40:100504), demostramos que el cambio climático prolongará los cuadros de flavobacteriosis, dado que el agua permanecerá entre 8 y 15 °C durante más tiempo, rango óptimo para el desarrollo del patógeno.
Por todo esto, se requiere una mayor apertura de productores y reguladores para conversar con base en la evidencia científica sobre la situación de la flavobacteriosis, evaluando la factibilidad de establecer un Programa Activo. No se trata solo de considerar los costos económicos para los productores, sino también de evaluar el impacto de los antimicrobianos y los beneficios que se obtendrían respecto a la calidad de los smolt y su estatus sanitario al llegar al mar.
El Policy Brief tampoco consideró la situación del BKD y de su agente, Renibacterium salmoninarum, lo que hoy debería analizarse con la evidencia científica disponible, incluidos los resultados de dos proyectos FONDECYT. Esto permitiría evaluar si el Programa de Screening de Reproductores y los métodos diagnósticos cumplen su objetivo principal: evitar que los peces estén infectados. Los datos productivos, especialmente en Magallanes, indican que no se estarían cumpliendo los resultados esperados. Actualmente, este patógeno es la primera causa de uso de antimicrobianos en agua dulce, algo que no ocurría en 2020.

En 2024, el 9,3% de las muertes de salmón del Atlántico se originó por causas patógenas. La flavobacteriosis representó un 31,1 % de ese total, lo que corresponde a un 6% menos que en 2023. Esta baja se explica por el uso de antimicrobianos, cuyo consumo, sin embargo, aumentó de 338,9 toneladas en 2023 a 351,1 toneladas en 2024.
Entre 2017 y 2021 se registró una disminución anual cercana al 25% en el uso de antimicrobianos. Pero en 2024 hubo un incremento de 1,35 toneladas, con un hecho preocupante: en agua dulce se emplea mayoritariamente oxitetraciclina (5,35 toneladas), un antibiótico cuyo uso en mar está regulado y requiere documentación técnica para autorizar su uso extra-etiqueta. Esta situación debiera revisarse, considerando que F. psychrophilum es una bacteria extracelular que puede controlarse con medidas de prevención e infraestructura, como ocurre en otros países productores de salmónidos.
También es clave mantener la vigilancia de la susceptibilidad de los aislados bacterianos de F. psychrophilum y R. salmoninarum, tarea que realiza el IFOP. No obstante, la información obtenida debe usarse para decidir si se justifica un tratamiento. Los valores de corte epidemiológico, que permiten caracterizar un aislado de campo, deberían revisarse al menos cada dos años.
Finalmente, resulta fundamental evaluar la eficacia real de los tratamientos antimicrobianos aplicados por vía oral. Esta medida debiera ser obligatoria en la prescripción veterinaria cada vez que una piscicultura solicite alimento medicado, lo que aseguraría una aplicación responsable y basada en resultados.